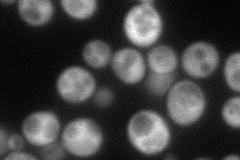
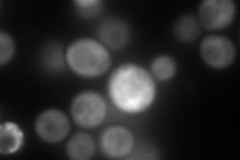
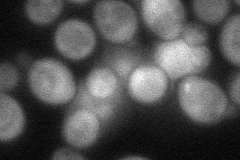
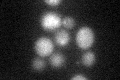

View description
Isocitrate lyase, catalyzes the formation of succinate and glyoxylate from isocitrate, a key reaction of the glyoxylate cycle; expression of ICL1 is induced by growth on ethanol and repressed by growth on glucose
Localization:
Intensity:
Fold change:
Significance:
-
C’ GFP library in SD

below threshold14.96 -
N' NOP1pr-GFP in SD
cytosol126.378 -
N' TEF2pr-mCherry in SD
cytosol166.856 -
N' NATIVEpr-GFP in SD

below threshold21.6075 -
N' TEF2pr-VC and Cyto-VN in SD
cytosol71.4568 -
C’ GFP library in SD+DTT
cytosol17.761.18No -
C’ GFP library in SD+H2O2

cytosol16.061.07No -
C’ GFP library in Starvation Media

cytosol18.461.23No -
C’ GFP library on the background of Pup2-DaMP

below threshold -
C’ GFP library on the background of CCT mutant

below threshold16.35841.09306No
